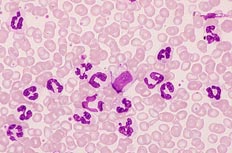

症例3
| 年齢 | 70歳代 | |||
|---|---|---|---|---|
| 現病歴 | 白血球増加を主訴に来院し、精査のために骨髄穿刺が施行された. 胸部X線、腹部エコー異常なし. |
|||
| 血液学所見 | WBC(/μL) | 52,000 | RBC(万/μL) | 542 |
| Hb(g/dL) | 12.5 | Ht(%) | 40.7 | |
| PLT(万/μL) | 14.5 | MCV(fL) | 75.1 | |
| MCH(pg) | 23.1 | MCHC(%) | 30.7 | |
| 血液像(%) | Promy 1,My 2,Met 2,St 6,Seg 88,Ly 1 | |||
| 骨髄所見 | NCC(万/μL) | 40.6 | MgK(/μL) | 156.25 |
| Blast(%) | 3.0 | |||
| 細胞化学所見 | NAP活性 (PS 476,PR 100%) | |||
| 生化学所見 | LDH 424 U/L, 尿酸 8.6mg/dL,VB12 6,100pg/dL, 血清リゾチーム 72.3μg/mL, |
|||
![]() |
![]() |
|
|---|---|---|
| [末梢血×400.MG染色] 白血球の著増は成熟好中球が優位である. |
[末梢血×1000.MG染色] 成熟好中球は48,880/μLと増加して、全般に顆粒の出現が少ない. |
|
![]() |
![]() |
|
| [骨髄×400.MG染色] 顆粒球系細胞が優位で、赤芽球が抑制されている. |
[骨髄×1000.MG染色] 末梢血と同様に好中球の増加がみられる. |
|
![]() |
||
| [末梢血×400.NAP染色] 好中球はNAP染色に陽性である. |
||
| 下記の中から答えをお選びください。 | |
| 1 | 慢性好中球性白血病(CNL) |
|---|---|
| 2 | 慢性骨髄単球性白血病(CMML) |
| 3 | 慢性骨髄性白血病(CML) |
| 4 | 骨髄異形成腫瘍(MDS) |
| 5 | 非定型性慢性骨髄性白血病(aCML) |